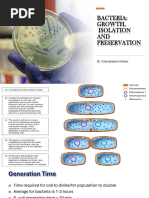

SYNCHRONOUS GROWTH: Synchronous Culture
Synchronous growth of a bacterial population is that during which all bacterial cells of the
population are physiologically identical and in the same stage of cell division cycle at a
given time. Synchronous growth helps studying particular stages or the cell division cycle
and their interrelations.
In most of the bacterial cultures the stages of growth and cell division cycle are completely
random and thus it becomes difficult to understand the properties during the course of division
cycle using such cultures. To overcome this problem, the microbiologists have developed
synchronous culture techniques to find synchronous growth of bacterial population. Synchronous
culture is that in which the growth is synchronous i.e, all the bacterial cells of the population are
physiologically identical and in the same stage of cell division cycle at a given time
A synchronous culture can be obtained either by manipulating environmental conditions such as
by repeatedly changing the temperature or by adding fresh nutrients to cultures as soon as they
enter the stationary phase, or by physical separation of cells by centrifugation or filtration
An excellent and most widely used method to obtain synchronous cultures is the Helmstetter-
Cummings Technique in which an unsynchronized bacterial culture is filtered through
cellulose nitrate membrane filter.
Helmstetter Cumming technique of Obtaining synchronous cultures
1. Culture 2. Filter 3. Fresh Medium 4. Baby Cells
The loosely bound bacterial cells are washed from the filter, leaving some cells tightly associated
�with the filter. The filter is now inverted and fresh medium is allowed to flow through it. New
bacterial cells, that are produced by cell division and are not tightly associated with the filter, are
washed into the effluent. Hence, all cells in the effluent are newly formed and are, therefore, at
the same stage of growth and division cycle. The effluent thus represents a synchronous culture.
Synchronous Growth of Bacteria
Studying the growth of bacterial populations in batch or continuous cultures does not permit any conclusions about the
growth behavior of individual cells, because the distribution of cell size (and hence cell age) among the members of the
population is completely random. Information about the growth behavior of individual bacteria can, however, be
obtained by the study of synchronous cultures. Synchronized cultures must be composed of cells which are all at the
same stage of the bacterial cell cycle. Measurements made on synchronized cultures are equivalent to measurements
made on individual cells.
A number of techniques have been devised to obtain bacterial populations at the same stage in the cell cycle. Some
techniques involve manipulation of environmental parameters which induces the population to start or stop growth
at the same point in the cell cycle, while others are physical methods for selection of cells that have just completed the
process of binary fission. Theoretically, the smallest cells in a bacterial population are those that have just
completed the process of cell division. Synchronous growth of a population of bacterial cells is illustrated in Figure
5. Synchronous cultures rapidly lose synchrony because not all cells in the population divide at exactly the same
size, age or time.
Figure 5. The synchronous growth of a bacterial population. By careful selection of cells that have
just divided, a bacterial population can be synchronized in the bacterial cell division cycle.
Synchrony can be maintained for only a few generations.